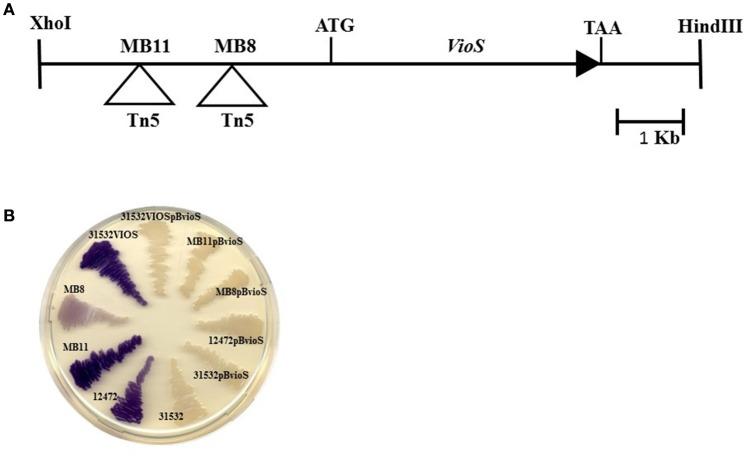
https://cdn.ncbi.nlm.nih.gov/pmc/blobs/5e98/5339254/2afbd7dc2b49/fmicb-08-00349-g0001.jpg

在……中紫菌素生物合成的负调控
Negative Regulation of Violacein Biosynthesis in .
作者信息
Devescovi Giulia, Kojic Milan, Covaceuszach Sonia, Cámara Miguel, Williams Paul, Bertani Iris, Subramoni Sujatha, Venturi Vittorio
机构信息
International Centre for Genetic Engineering and Biotechnology Trieste, Italy.
Laboratory for Molecular Microbiology, Institute of Molecular Genetics and Genetic Engineering, University of Belgrade Belgrade, Serbia.
出版信息
Front Microbiol. 2017 Mar 7;8:349. doi: 10.3389/fmicb.2017.00349. eCollection 2017.
In , the purple pigment violacein is under positive regulation by the -acylhomoserine lactone CviI/R quorum sensing system and negative regulation by an uncharacterized putative repressor. In this study we report that the biosynthesis of violacein is negatively controlled by a novel repressor protein, VioS. The violacein operon is regulated negatively by VioS and positively by the CviI/R system in both and in a heterologous genetic background. VioS does not regulate the CviI/R system and apart from violacein, VioS, and quorum sensing regulate other phenotypes antagonistically. Quorum sensing regulated phenotypes in are therefore further regulated providing an additional level of control.
在[具体情况未提及]中,紫色色素紫菌素受到酰基高丝氨酸内酯CviI/R群体感应系统的正调控以及一种未鉴定的假定阻遏物的负调控。在本研究中,我们报告紫菌素的生物合成受到一种新型阻遏蛋白VioS的负调控。紫菌素操纵子在[具体情况未提及]以及异源[具体情况未提及]遗传背景下均受到VioS的负调控和CviI/R系统的正调控。VioS不调控CviI/R系统,并且除了紫菌素、VioS和群体感应外,还对其他表型产生拮抗调控作用。因此,[具体情况未提及]中群体感应调控的表型受到进一步调控,提供了额外的控制水平。